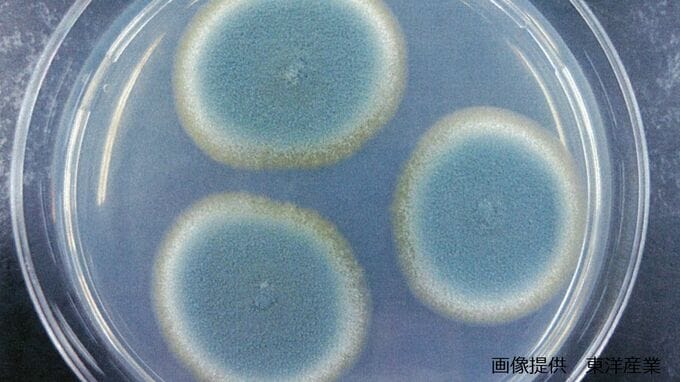

お正月に用意した餅にカビが生えて来た…というご家庭があるかもしれません。
カビが生えたらカビの部分を削り取って食べるという話を時折耳にしますが、大丈夫なのでしょうか。
害虫駆除や環境衛生保全に詳しい東洋産業の大野竜徳さんに聞きました。
ーカビの生えた餅は、カビを取り除けば食べても問題ないのでしょうか。
(東洋産業 大野竜徳さん)
「カビの生えたお餅ですが、『食べないほうがいい』というのは確かにそうです。カビが生えているのが確認できるのは、
「【画像①】は、一番身の回りに多い『アオカビ』です。食パンやお餅、みかんが大好きで、
「菌糸(【画像②】)は、細い半透明の糸、

「菌糸の部分はほとんどの場合、目には見えません。カビの根っこ、と表現されることもある部位ですね。なので、見える部分を削って洗っても、カビの生えた部分(菌糸)
「しっかり削って洗ったにもかかわらず、味に『なんか粉っぽい』『かびっぽい』風味がするというのはそれに由来します」